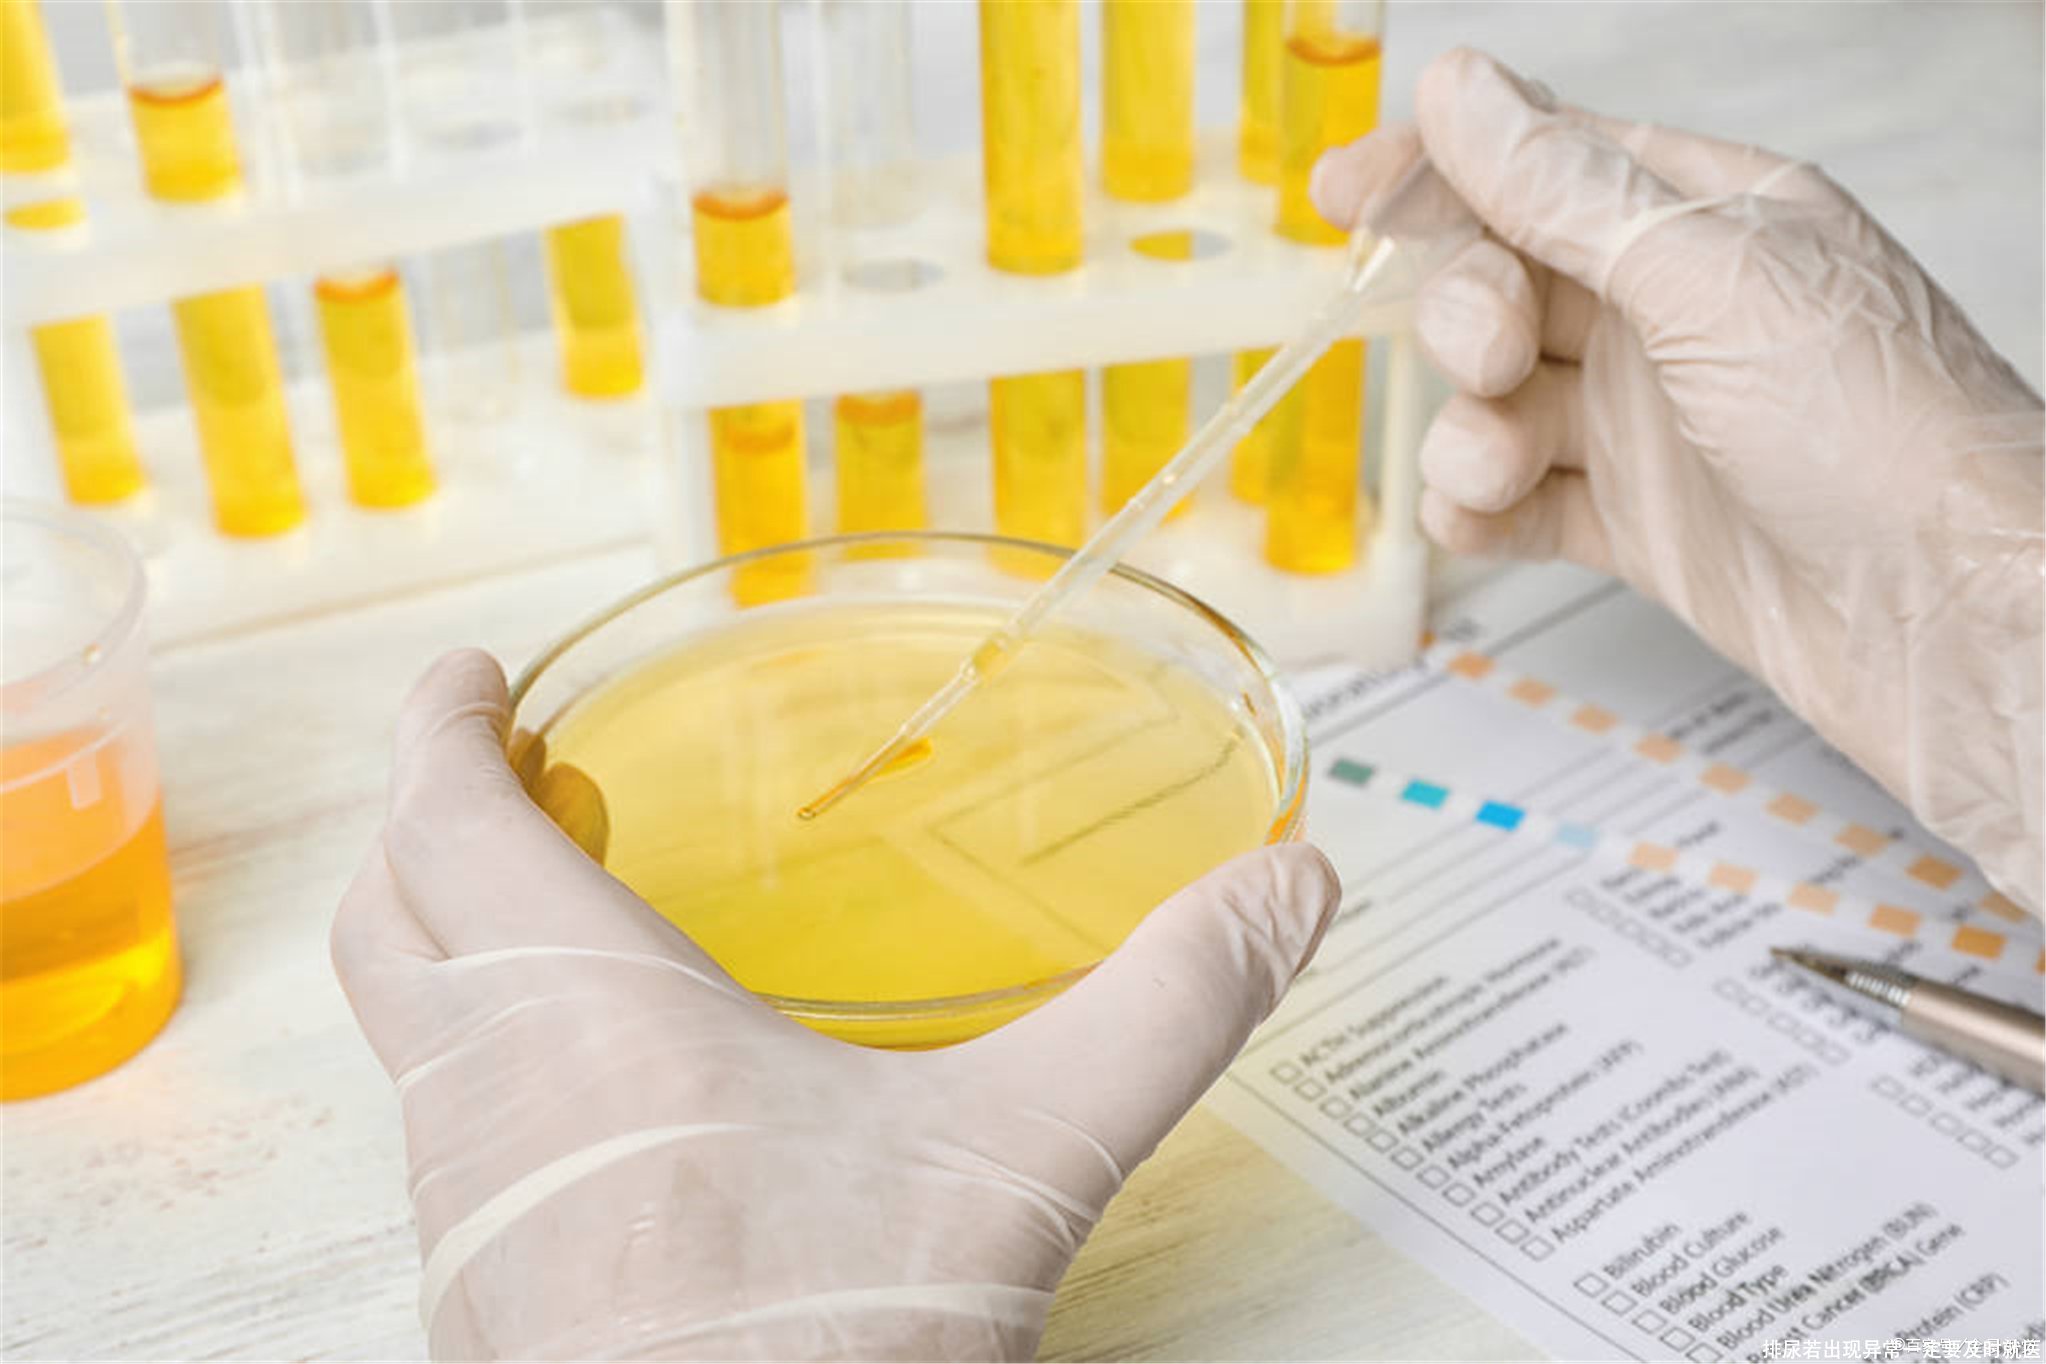
排尿若出现异常一定要及时就医

您现在的位置是:生活百科网 > 生活百科 >
排尿若出现异常一定要及时就医
2023-08-12 18:21生活百科 人已围观
简介排尿时若发现4个变化,应尽早检查身体保持健康,泌尿系统维持功能良好,在排尿的过程中顺利,排泄出来的尿液不会有特殊表现。如果发现尿液有颜色,气味或者状态的变化,还需警...
排尿时若发现4个变化,应尽早检查身体保持健康,泌尿系统维持功能良好,在排尿的过程中顺利,排泄出来的尿液不会有特殊表现。如果发现尿液有颜色,气味或者状态的变化,还需警惕,不排除是某些疾病在发展,需要通过对症治疗让疾病带来的影响减轻,否则某些病变不断发展,可能会增加治疗难度。那么,通过尿液变化是否就可以得知身体健康情况呢?

以尿为镜,可知健康。想要了解是否有某些器官出现了器质性病变,可以通过尿液变化来得知。很多人身体代谢紊乱,红细胞或者蛋白质流失,尿液中有特殊表现。另外,身体的有害物质无法排泄,尿液气味还会变化,确实可以通过排尿情况了解身体健康程度。
排尿有哪些情况需警惕?
1、排出如茶色尿液
在排尿的过程中出现了如茶色尿液,应该马上检查。因为正常的尿液为清澈透明状,饮水量过少尿液浓缩,可能颜色会发黄,但是很少出现如茶色的尿液。有这种情况出现需要警惕疾病,很可能是肝脏发生病变。肝脏细胞变性,坏死,释放到血液中的胆红素多,出现了黄疸之后明显的特点就是如茶色尿液出现,这种情况应该积极展开治疗。
2、尿液量过少
在排尿的过程中发现尿液量少,无法顺利将尿液排泄出体外,也是疾病出现。那些肾脏有病变的人身体水分排泄受阻,在尿液排泄量少,有害物质无法顺利排泄出体外时健康会受影响,就算增加饮水量尿液排泄量依然少。有这种情况出现应该针对肾脏病变展开治疗,才能恢复身体健康,让水钠滞留情况改善。
3、出现蛋白尿
排尿的过程中发现有很多泡沫,需要提高警惕,很可能是蛋白质流失。部分肾脏疾病会让患者的肾小球滤过功能受影响,蛋白质随着尿液排泄出体外,在成分改变之后会有不消散的泡沫出现。很多人看到泡沫尿认为只是尿液浓缩或者纳入的空气多引起,殊不知蛋白质流失也会有这种表现。

4、排出血尿
排尿出现颜色的改变,有肉眼可见的血尿,应该及时检查。因为导致血尿出现的疾病类型较多,例如肾脏疾病、前列腺疾病、膀胱病变,这些类型的疾病发展过程中局部粘膜受损出血,或者血管受到损伤而血液流失,在红细胞跟尿液混合后会颜色改变,不再保持尿液清澈透明状,而是有尿液发红的特点,这种情况也需要警惕疾病入侵。
近年来,随着生活水平的提高和医疗技术的不断进步,人们对健康的关注度也越来越高。然而,令人担忧的是,许多人往往忽视了身体的一些细微变化,这些变化可能是身体内部发生问题的信号。在我们日常生活中,排尿是一个非常常见的生理过程。如果我们能够注意到排尿中的一些变化,也许可以及早发现一些潜在的健康问题,从而避免疾病的进一步恶化。本文将介绍并分析五个与排尿相关的变化,以便读者及时检查自己的身体状况。
第一个变化是排尿频率的改变。正常情况下,大多数人的排尿频率较为稳定,每天大约是6-8次。然而,如果你发现自己的排尿频率明显增加或减少,那么这就有可能是一个警示信号。增加的排尿频率可能是尿道感染、膀胱问题或糖尿病等问题的表现。减少的排尿频率则可能是膀胱功能异常、肾脏问题或尿液积聚的结果。如果你发现自己有明显的排尿频率改变,应及早向医生咨询,以了解是否需要进一步检查。
第二个变化是排尿的疼痛或刺激感。正常情况下,排尿应该是一个无痛的过程。然而,如果你在排尿时出现剧烈疼痛、灼烧感或尿道刺激感,那么这就可能是尿路感染、膀胱结石或尿道炎症等疾病的表现。此外,排尿时的疼痛还可能与肾脏疾病、盆腔炎症或肿瘤等问题有关。如果你感到排尿过程中的疼痛或刺激感明显,应尽快就医,以便进行相关检查和治疗。
第三个变化是尿液的颜色改变。正常情况下,尿液的颜色应该是透明或淡黄色。然而,如果你发现自己的尿液变得深黄色、浑浊、带有血丝或其他颜色的变化,那么这就有可能是肾脏问题、尿路感染、肝功能异常或其他疾病的表现。此外,一些药物或补充剂的使用也可能导致尿液颜色的变化。如果你发现自己的尿液颜色异常,特别是伴随其他症状的出现,应去医院接受检查,以了解问题的原因。
第四个变化是尿液的气味改变。正常情况下,尿液的气味应该是淡淡的,几乎没有气味。但是,如果你闻到自己的尿液有强烈的气味,例如酸臭味、果味或者腐臭味,那么这可能是尿道感染、泌尿系统感染或其他疾病的表现。此外,一些食物和药物的摄入也可能导致尿液气味的改变。如果你发现自己的尿液有明显的气味变化,并且伴随其他异常症状,应及时寻求医生的帮助,以进行针对性的检查和治疗。
第五个变化是尿液排出的量的改变。正常情况下,每次排尿的量应该是适量的,大约是200-400毫升。然而,如果你发现自己排尿的量明显减少或增多,那么这可能是肾脏问题、膀胱问题或者尿液潴留等疾病的表现。排尿量的减少可能与脱水、肾功能受损或其他疾病有关。排尿量的增多可能与多尿症、尿液过多或者糖尿病有关。如果你发现自己的尿液排出量有异常变化,应及时就医,以便了解原因并进行相应的治疗。
总之,排尿的变化可能是身体内部出现问题的信号。因此,每个人都应该关注自己的排尿状况,并留意其中的变化。如果你发现排尿频率、疼痛感、尿液颜色、尿液气味或尿液量等方面发生了明显的改变,应及早向医生咨询,并接受相关的检查和治疗。只有及早发现和处理潜在的健康问题,我们才能够维持良好的身体状况,提高寿命的质量和长度。
下一篇:女性长期喝咖啡的利弊
相关文章
- 2023北京本科普通批985院校投档线:清华685、北大683、武大653分
- 广东考生上华南理工大学难吗?
- 上海这3所大学2023考研复试分数线公布
- 最大相差178分!南京理工大学投档线集锦!最高681分,最低503分
- 2023湖北物理类投档线:武科大573、湖大563、江大536、武体506分
- 多少分能上南大?2023南京大学在苏录取数据盘点,这些途径可以走
- 2023山东高考,省内分数线最高的十所大学
- 国防科技大学录取分数线是多少?附国防科技大学毕业去向
- 郑州大学多少分能考上?2024才可以录取?附最低分数线
- 北京航空航天大学2023年录取分数线及省排名
- 哈尔滨工业大学(威海)、(深圳)校区2023年录取分数情况
- 2023广东本科投档线出炉!请看中大/华工/深大/华师/暨大等分数线
随机图文

什么的田野填合适的词(什么的田野填合适的词二年级下册)
仓廪实,天下安。关心民生冷暖,关注粮食生产,一直是习近平总书记外出考察...
教育部颁布《普通话水平测试管理规定》,2022年1月1日起施行
近日,教育部颁布新修订的《普通话水平测试管理规定》,删除两次测试间隔时...
余罪第二季在线观看 余罪第二季在线观看完整版不卡
大家好,感谢邀请,今天来为大家分享一下余罪第二季在线观看的问题,以及和...
表达好久不见的句子(表达好久不见的朋友相聚的句子)
表达好久不见的句子??写在作文开头的25个神仙句子秘?|||哈喽,宝贝们,好久不...
广汽三菱正式宣布重组!想买欧蓝德的朋友抓紧,终端能优惠2万起
终于,在10月24日,广汽集团董事会审议通过了《关于广汽三菱重组的关联交易...
吃重阳糕(吃重阳糕代表什么意义)
吃重阳糕题念济寺晕上人院卢纶,花朝节———节日里的古诗词盛宴。题解卢纶...
张嘉译电视剧大全(张嘉译电视剧大全)
提起男演员张嘉译,他是国内演艺圈中最具实力也是最具人气的中年男演员之一...
农村人在家干什么挣钱(在农村干什么挣钱致富有哪些)
陕西省商洛市最大的资源就是林地多、山地多,林地资源丰富,农民如果不出去...